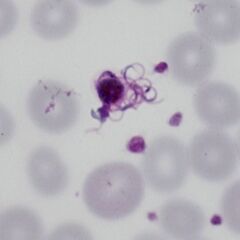

Re-infection of the mosquito
From MalariaETC
Navigation
>Main Malaria Index
>>Malaria Biology Index
>>>Current page: Sexual replication
The initial infection of the host
When a mosquito feeds from a malaria infected host, the blood meal will contain parasites of all forms. Importantly these forms include male and female gametocytes. The pH and temperature changes with the mosquito midgut cause the gametocytes to gain full sexual maturity (gametogenesis). The male gametocyte then undergoes 3 cycles of division to generate 8 male sexual forms (gametes). These then 8 gametes then "break out" of the male microgametocytes in a process known as exflagellation, and fuse with the female oocyte (derived from the macrogametocyte). Then following successful fusion move to the next stage of development with the mosquito gut wall. Finally the parasite enter the salivary glands of the mosquito as sporozoites where a new infection can be initiated.
If samples of blood undergo delayed spreading then the changes to pH and temperature caused by storage may partly mimic the conditions within the mosquito midgut leading to changes that would only normally be seen in the mosquito. Some may be difficult to recognise but are clearly atypical in appearance, others such as "exflagellation" have very clear appearances. It is important to be able to recognise these forms as they can cause confusion and mis-diagnosis.
The gametes of P.falciparum are seen in the process of exflagellation from the male gametocyte in a sample that has undergone delayed processing
|